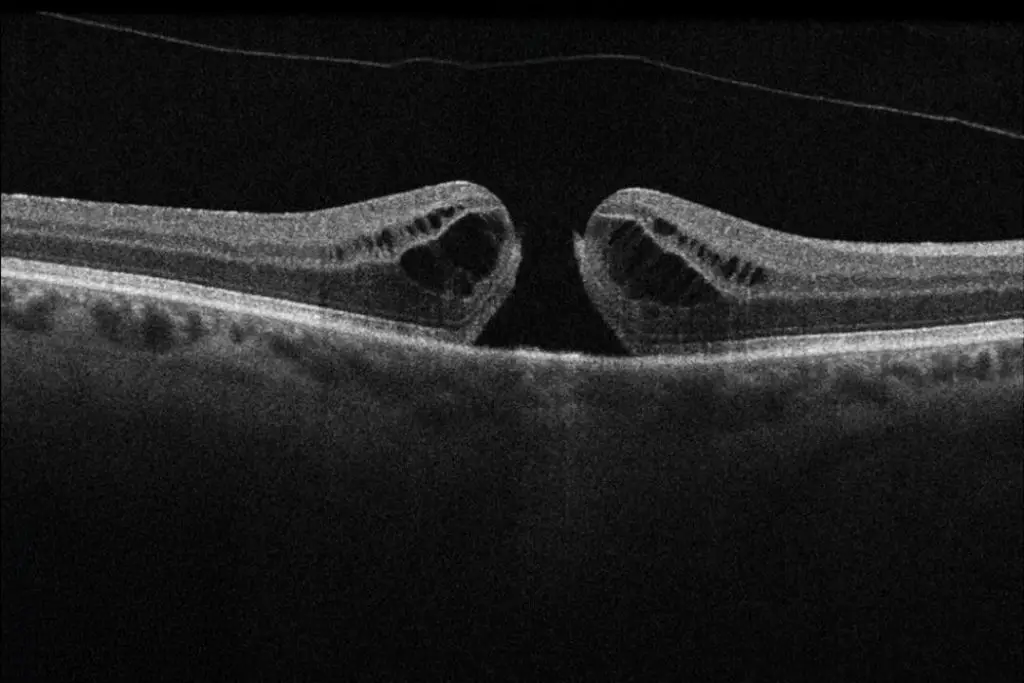

Grauer Star (Katarakt) – Was ist das?
Der Graue Star (Katarakt) ist eine trübe Linse im Auge, die das Sehen nach und nach verschlechtert. Normalerweise ist die Augenlinse klar und sorgt für scharfes Sehen. Beim Grauen Star wird sie jedoch undurchsichtig, wodurch die Sicht verschwommen und unscharf wird – ähnlich wie durch eine beschlagene Fensterscheibe.
Symptome des Grauen Stars
- Verschwommenes Sehen als ob ein Schleier über dem Auge liegt
- Blendungsempfindlichkeit – besonders bei hellem Licht oder nachts
- Farben erscheinen blasser oder gelblich
- Schlechte Sicht in der Dämmerung oder Dunkelheit
- Häufige Änderung der Brillenstärke, ohne dass es besser wird
Warum entsteht ein Grauer Star?
- Natürliches Altern häufig ab 60 Jahre
- UV-Strahlung ungeschützte Sonneneinstrahlung auf die Augen
- Diabetes erhöhtes Risiko für eine frühzeitige Linsentrübung
- Rauchen und Alkohol schädigen die Linsenzellen
- Langfristige Medikamenteneinnahme, z.B. Kortison
- Augenverletzungen oder Entzündungen
Was kann man gegen Grauer Star tun?
Die Katarakt-OP ist der häufigste und sicherste Eingriff in der Augenheilkunde. Dabei wird die trübe Linse entfernt und durch eine künstliche Linse ersetzt. Die OP dauert nur ca. 15–20 Minuten, ist schmerzfrei und wird meist ambulant durchgeführt. Nach der Heilung kann das Sehen oft sogar besser als zuvor sein!
Unser Fazit
Ein Grauer Star ist kein Grund zur Sorge, aber er sollte nicht ignoriert werden. Bei Verschwommensehen oder Blendempfindlichkeit hilft eine Augenuntersuchung, um Klarheit zu schaffen. Dank moderner Chirurgie kann das Sehvermögen dauerhaft wiederhergestellt werden – für eine klare Sicht und mehr Lebensqualität!
PentaCam
Die Pentacam ermöglicht eine berührungslose, dreidimensionale Analyse des vorderen Augenabschnitts – inklusive Hornhaut, Vorderkammer und Linse. Dank modernster Scheimpflug-Technologie liefert sie hochpräzise Daten, die entscheidend für refraktive Eingriffe (z. B. LASIK), die Keratokonus-Diagnostik und die Anpassung spezieller Kontaktlinsen sind.
Die Untersuchung ist schmerzfrei und dauert nur wenige Minuten.

Funktionen und Messungen der Pentacam:
- Hornhauttopographie & -tomographie – Erfassung der Hornhautdicke, -krümmung und -struktur zur Diagnose von Keratokonus oder zur Planung von Augenoperationen (z. B. LASIK).
- Pachymetrie (Hornhautdickenmessung) – Wichtige Messung für Glaukomdiagnostik und refraktive Chirurgie.
- Vorderkammeranalyse – Bewertung der Kammerwinkelweite, hilfreich für Glaukom-Risikoabschätzung.
- Linsentransparenz-Analyse – Erkennung einer beginnenden Katarakt (Grauer Star) durch Messung der Linsentrübung.
- Belin/Ambrosio-Enhancement-Display – Spezialanalyse zur Früherkennung von Hornhaut-Erkrankungen oder zur Beurteilung der Eignung für refraktive Chirurgie.
Einsatzgebiete der Pentacam:
- Vorbereitung von Augenoperationen (z. B. LASIK, Linsenimplantate, Keratoplastik)
- Diagnose von Hornhauterkrankungen (Keratokonus, Hornhautdystrophien)
- Glaukom-Früherkennung (Messung der Kammerwinkel und Hornhautdicke)
- Katarakt-Diagnostik (Analyse der Linsentrübung)
Optische Kohärenztomographie
Die Optische Kohärenztomographie (OCT) ist ein hochauflösendes, nicht-invasives Bildgebungsverfahren, das zur detaillierten Untersuchung der Netzhaut, des Sehnervs und der vorderen Augenabschnitte eingesetzt wird.
Sie basiert auf Lichtwelleninterferometrie und ermöglicht die Schicht-für-Schicht-Darstellung der Netzhaut in mikroskopischer Detailgenauigkeit.
Funktionen und Anwendungen der OCT:
- Netzhautdiagnostik: Erkennung und Verlaufskontrolle von Makuladegeneration (AMD), diabetischer Retinopathie, Makulaödem, Makulaforamen u. a.
- Glaukomdiagnostik: Vermessung des Sehnervenkopfes (Papille) und der Nervenfaserschicht, um Schäden frühzeitig zu erkennen.
- Vorderabschnitts-OCT: Untersuchung der Hornhaut, der Vorderkammer und des Kammerwinkels bei Erkrankungen wie Keratokonus oder Glaukom.
- Beurteilung von Netzhautablösungen und epiretinalen Membranen.
- Operationsplanung und Nachkontrolle: Bewertung der Netzhaut vor und nach intravitrealen Injektionen (IVOM), Katarakt-OP oder vitreoretinalen Eingriffen.
Vorteile der OCT:
- Berührungslos & schmerzfrei – keine Injektionen oder Kontrastmittel erforderlich
- Extrem hohe Auflösung (bis zu wenige Mikrometer) für präzise Diagnosen
- Schnelle Untersuchung – dauert meist nur wenige Sekunden
- Früherkennung von Netzhaut- und Sehnervenerkrankungen, noch bevor Symptome auftreten
Endothelzellmikroskop
Das Endothelzellmikroskop ist ein spezialisiertes Diagnosegerät zur Untersuchung der Hornhautendothelzellen, die für die Transparenz und Flüssigkeitsregulation der Hornhaut verantwortlich sind. Es ermöglicht eine quantitative und qualitative Analyse der Endothelzellen, um Erkrankungen frühzeitig zu erkennen.
Das Endothelzellmikroskop ist ein essentielles Diagnosewerkzeug, um die Gesundheit der Hornhaut zu beurteilen und Komplikationen nach Augenoperationen frühzeitig zu erkennen.

Funktionen und Messwerte des Endothelzellmikroskops:
- Zellanzahl (Endothelzelldichte, ECD): Normalerweise 2.000–3.000 Zellen/mm², ein Rückgang deutet auf Hornhautschäden hin.
- Zellform (Polymegethismus): Unregelmäßige Zellgrößen können auf Endothelschädigung hindeuten.
- Zellgröße (Pleomorphismus): Hohe Variabilität der Zellform weist auf eine Hornhautdekompensation hin.
- Beurteilung der Endothelintegrität: Wichtig vor Augenoperationen (z. B. Katarakt-OP, LASIK, Hornhauttransplantation).
Einsatzgebiete des Endothelzellmikroskops:
- Diagnose von Fuchs-Endotheldystrophie (degenerative Erkrankung des Endothels)
- Überwachung nach Katarakt-OP (Prüfung, ob die Hornhaut geschädigt wurde)
- Kontrolle bei Kontaktlinsenträgern (Langzeitkontaktlinsen können Endothelzellen schädigen)
- Beurteilung vor Hornhauttransplantationen (DMEK, DSAEK)
Vorteile der Endothelzellmikroskopie:
- Nicht-invasiv & schmerzfrei
- Früherkennung von Hornhautschäden, bevor Symptome auftreten
- Wichtige Entscheidungshilfe für chirurgische Eingriffe

Grüner Star (Glaukom) – stille Gefahr für das Auge
Symptome des Grünen Stars
- Frühe Stadien: Oft keine Beschwerden – daher ist eine regelmäßige Kontrolle wichtig!
Spätere Stadien:
- Eingeschränktes Gesichtsfeld – zuerst an den Rändern, später auch zentral
- Unscharfes Sehen und schlechtere Orientierung
- Erhöhte Blendempfindlichkeit
- Farben erscheinen blasser
- Druckgefühl oder Schmerzen (bei bestimmten Glaukomformen)
Warum entsteht ein Glaukom?
Der häufigste Grund ist ein erhöhter Augeninnendruck, der den Sehnerv schädigt. Aber auch Durchblutungsstörungenoder genetische Veranlagung spielen eine Rolle.
- Erhöhter Augeninnendruck (durch gestörten Abfluss des Kammerwassers)
- Vererbung – höheres Risiko, wenn enge Verwandte betroffen sind
- Alter – meist ab 40 Jahren, Risiko steigt mit dem Alter
- Diabetes & Herz-Kreislauf-Erkrankungen – beeinflussen die Durchblutung des Sehnervs
- Lange Kortison-Einnahme Medikamenteneinnahme– kann den Augeninnendruck erhöhen
Da der Grüne Star schleichend und ohne Schmerzen beginnt, wird er oft erst spät bemerkt. Regelmäßige Augenuntersuchungen ab 40 Jahren können helfen, ihn frühzeitig zu erkennen!
Was kann man gegen ein Glaukom tun?
Das Ziel der Behandlung ist es, den Augeninnendruck zu senken, um den Sehnerv zu schützen.
-
Möglichkeiten:
- Augentropfen – senken den Druck und verbessern die Durchblutung
- Laserbehandlung – verbessert den Abfluss des Kammerwassers
- Glaukom-Operation (z. B. iStent, Trabekulektomie) – wenn Tropfen nicht ausreichen
Unser Fazit
Makuladegeneration
Altersabhängige Makuladegeneration (AMD) – kurz erklärt:
AMD ist eine Augenerkrankung, die vor allem ältere Menschen betrifft und das zentrale Sehen verschlechtert. Die Makula, der Bereich der Netzhaut für das scharfe Sehen, wird dabei geschädigt. Es gibt zwei Hauptformen, die trockene und die feuchte Makuladegeneration:

Trockene Makuladegeneration
Diese langsam fortschreitende Form betrifft ca. 80 % der AMD-Fälle.
Es lagern sich Stoffwechselreste (Drusen) unter der Netzhaut ab, was mit der Zeit die Sehzellen schädigt.
Anfangs gibt es oft keine Symptome, später werden Lesen und Gesichtserkennung schwieriger.
Eine Heilung gibt es nicht, aber eine gesunde Lebensweise (gute Ernährung, kein Rauchen) kann das Risiko senken.
Feuchte Makuladegeneration
Diese seltenere, aber aggressivere Form entsteht durch neue, undichte Blutgefäße unter der Netzhaut, die Flüssigkeit und Blut austreten lassen.
Das führt zu Schwellungen, verzerrtem Sehen (z. B. wellige Linien) und schnellem Sehverlust.
Die Behandlung erfolgt mit Medikamenten, die das Gefäßwachstum stoppen. Diese werden direkt ins Auge gespritzt und können das Fortschreiten verlangsamen oder sogar die Sehkraft verbessern.
Früherkennung ist wichtig: Regelmäßige Augenuntersuchungen helfen, AMD früh zu erkennen und rechtzeitig zu behandeln.
Behandlung der feuchten AMD mit IVOM – kurz erklärt:
Die intravitreale Medikamenteneingabe (IVOM) ist eine bewährte Therapie für die feuchte AMD. Dabei wird ein Medikament direkt ins Auge gespritzt, um das Wachstum schädlicher Blutgefäße zu stoppen. Das kann den Sehverlust verlangsamen oder sogar die Sehkraft verbessern.
Die Behandlung ist schmerzfrei, da das Auge örtlich betäubt wird. Da die feuchte AMD chronisch ist, sind oft mehrere Injektionen nötig. Regelmäßige Untersuchungen helfen, den Therapieerfolg zu überwachen und die Behandlung anzupassen.

Fluoreszenzangiographie
Die Fluoreszenzangiographie (FAG) ist ein diagnostisches Bildgebungsverfahren, das zur Untersuchung der Blutgefäße der Netzhaut und Aderhaut eingesetzt wird.
Sie wird vor allem zur Diagnose und Verlaufskontrolle von Netzhauterkrankungen verwendet.
Ablauf der Fluoreszenzangiographie:
- Fluoreszein-Injektion: Ein farbstoffhaltiges Kontrastmittel (Fluoreszein) wird in eine Armvene gespritzt.
- Verteilung im Auge: Der Farbstoff zirkuliert durch die Blutgefäße der Netzhaut und Aderhaut.
- Bildaufnahme: Eine Spezialkamera macht in kurzen Abständen hochauflösende Bilder, die undichte oder verengte Gefäße sichtbar machen.
Indikationen – Wann wird eine FAG durchgeführt?
- Altersbedingte Makuladegeneration (AMD) – Erkennung von undichten Gefäßen bei feuchter AMD.
- Diabetische Retinopathie – Feststellung von Gefäßveränderungen oder Durchblutungsstörungen.
- Gefäßverschlüsse der Netzhaut – Diagnose von Venen- oder Arterienverschlüssen.
- Entzündliche Augenerkrankungen – Untersuchung von Gefäßentzündungen (z. B. Uveitis).
- Tumorerkrankungen im Auge – Abklärung von Gefäßmustern in Tumoren.
Vorteile der Fluoreszenzangiographie:
- Hochpräzise Darstellung der Netzhautgefäße
- Früherkennung von Durchblutungsstörungen
- Hilft bei Therapieentscheidungen, z. B. für IVOM-Injektionen (Anti-VEGF)
Mögliche Nebenwirkungen:
- Vorübergehendes Gelbfärben der Haut & des Urins (durch Fluoreszein).
- Gelegentlich Übelkeit oder allergische Reaktionen.
Makulaerkrankungen
Wenn die Sehmitte betroffen ist
Epiretinale Gliose
Epiretinale Gliose („Zellophanmakulopathie“) – Wenn eine Membran die Netzhaut verzerrt.
Die epiretinale Gliose entsteht durch eine feine, narbige Membran, die sich auf der Makula bildet und diese langsam verzieht. Dies kann zu verschwommenem und verzerrtem Sehen (Metamorphopsien) führen.

Symptome der Epiretinale Gliose
- Gerade Linien erscheinen wellig oder verzogen
- Verschwommenes oder unscharfes Sehen
- Leichter bis mäßiger Sehverlust
Warum entsteht Epiretinale Gliose
- Altersbedingt (häufig ab 50)
- Nach Netzhautentzündungen oder Augenoperationen
- Netzhautrisse oder -ablösungen
- Nach Glaskörperabhebung
Was kann man gegen die Epiretinale Gliose tun?
Bei leichten Beschwerden ist meist keine Behandlung nötig. Bei starker Sehbeeinträchtigung kann eine Operation (Vitrektomie mit Membranpeeling) helfen, indem die störende Membran entfernt wird.
Makulaloch – Ein Loch in der Sehmitte
Ein Makulaloch ist ein Defekt in der Netzhautmitte, der das zentrale Sehen stark beeinträchtigt. Es entsteht, wenn sich der Glaskörper im Auge altersbedingt verändert und an der Makula zieht.
Symptome des Makulalochs
- Plötzlicher Verlust des zentralen Sehens
- Dunkler Fleck oder Loch in der Mitte des Gesichtsfelds
- Verzerrte Linien oder Buchstaben
Warum entsteht ein Makulaloch?
- Altersbedingte Glaskörperveränderungen (häufigste Ursache)
- Augenverletzungen oder Netzhauterkrankungen
- Hohe Kurzsichtigkeit
Was kann man gegen ein Makulaloch tun?
Ein Makulaloch heilt meist nicht von selbst. Die einzige wirksame Therapie ist eine Operation (Vitrektomie mit Gasfüllung), bei der der Glaskörper entfernt und das Loch durch ein Gas oder Öl geschlossen wird. Nach der OP kann sich das Sehvermögen deutlich verbessern.
Unser Fazit
Makulaerkrankungen wie epiretinale Gliose oder Makulalöcher können das zentrale Sehen erheblich beeinträchtigen. Eine frühe Diagnose durch eine Augenuntersuchung (z. B. OCT) hilft, rechtzeitig eine geeignete Behandlung einzuleiten und das Sehvermögen zu erhalten. Bei plötzlichen Sehverschlechterungen sollte immer ein Augenarzt aufgesucht werden!
Augenarztkontrollen bei Diabetes sind wichtig!
Diabetes kann die Augen schädigen – oft unbemerkt! Besonders gefährlich ist die diabetische Retinopathie, eine Netzhauterkrankung, die das Sehvermögen dauerhaft bedrohen kann. Da Diabetes oft lange keine Beschwerden verursacht, ist eine frühe Diagnose und regelmäßige Kontrolle beim Augenarzt entscheidend, um Sehschäden oder sogar Erblindung zu verhindern.
Bei erhöhtem Blutzucker werden die feinen Blutgefäße der Netzhaut geschädigt. Dies kann zu Durchblutungsstörungen, Gefäßaustritten oder Blutungen im Auge führen. Besonders betroffen ist die Makula, das Zentrum des scharfen Sehens.

Welche Augenkrankheiten sind bei Diabetes besonders häufig?
Diabetische Retinopathie – Schädigung der Netzhautgefäße, oft ohne Symptome in frühen Stadien.
Diabetisches Makulaödem – Flüssigkeitsansammlung in der Makula, die das Sehen verschwommen macht.
Erhöhtes Risiko für Grünen Star (Glaukom) – Durchblutungsprobleme am Sehnerv.
Frühzeitiger Grauer Star (Katarakt) – Trübung der Linse durch Diabetes.
Diabetes verursacht oft lange keine Beschwerden – Sehprobleme treten erst auf, wenn die Schädigung weit fortgeschritten ist! Deshalb sind regelmäßige Augenuntersuchungen so wichtig.
Früherkennung rettet das Sehvermögen – Je früher Veränderungen entdeckt werden, desto besser kann man gegensteuern.
Moderne Untersuchungen wie die OCT und Fluoreszenzangiographie helfen, kleinste Schäden sichtbar zu machen.
Bei rechtzeitiger Behandlung (z. B. mit Lasertherapie oder Medikamenten-Injektionen) kann die Sehfähigkeit erhalten werden.
Mindestens 1x pro Jahr zur Kontrolle – auch ohne Beschwerden!
Bei bereits vorhandener Retinopathie oder schlechter Blutzuckereinstellung sind häufigere Kontrollen nötig.
Diabetes kann die Augen schleichend schädigen – ohne frühzeitige Behandlung droht ein bleibender Sehverlust. Regelmäßige Augenuntersuchungen sind der beste Schutz für Ihr Sehvermögen! Vereinbaren Sie daher rechtzeitig Ihren nächsten Termin beim Augenarzt.
Regelmäßige Augenuntersuchungen
für Kinder und Jugendliche sind entscheidend
Gutes Sehen ist essenziell für die Entwicklung von Kindern und Jugendlichen. Doch viele Sehprobleme bleiben lange unbemerkt, weil Kinder oft nicht bemerken, dass ihr Sehen eingeschränkt ist.
Eine frühzeitige Diagnose und Behandlung kann schwerwiegende Folgen verhindern und die Sehfähigkeit nachhaltig verbessern.
Amblyopie – „Das träge Auge“ frühzeitig erkennen und behandeln
Die Amblyopie (Schwachsichtigkeit) ist eine der häufigsten Sehschwächen im Kindesalter. Sie entsteht, wenn das Gehirn ein Auge nicht richtig nutzt – oft verursacht durch Schielen oder unerkannte Fehlsichtigkeit. Wird die Amblyopie nicht frühzeitig erkannt und behandelt, kann das betroffene Auge dauerhaft schlechter sehen.
Früherkennung ist entscheidend! Je früher eine Amblyopie festgestellt wird, desto besser sind die Chancen auf eine erfolgreiche Therapie, z. B. mit Brillen, Augenpflastern oder speziellen Sehtrainings.
Myopie (Kurzsichtigkeit) – Die wachsende Herausforderung unserer Zeit
Kurzsichtigkeit nimmt weltweit stark zu – ein Trend, der besonders Kinder und Jugendliche betrifft. Ursachen sind neben genetischer Veranlagung vor allem der vermehrte Nahblick (Smartphones, Tablets, Computer) und zu wenig Zeit im Freien.
Unbehandelte oder stark fortschreitende Myopie kann langfristig das Risiko für Netzhautablösungen, Makuladegeneration und Glaukom erhöhen. Deshalb ist eine frühe Myopie-Kontrolle entscheidend, um die Sehkraft lebenslang zu schützen.
Myopie-Prophylaxe – Moderne Lösungen für besseres Sehen
Glücklicherweise gibt es heute innovative Methoden, um die Zunahme der Kurzsichtigkeit zu verlangsamen:
MiYOSMART-Brillengläser – Diese speziellen Gläser bremsen nachweislich das Fortschreiten der Myopie um bis zu 60%. Sie sind eine einfache und effektive Möglichkeit, die Sehentwicklung positiv zu beeinflussen.
Spezielle Kontaktlinsen (Orthokeratologie & Multifokallinsen) – Diese Kontaktlinsen helfen, das Wachstum des Augapfels zu regulieren und damit die Kurzsichtigkeit einzudämmen. Besonders Nachtlinsen (Ortho-K) haben sich bewährt, da sie über Nacht getragen werden und am Tag für scharfes Sehen ohne Sehhilfe sorgen.
Regelmäßige Augenuntersuchungen – Der Schlüssel zu gesunden Augen
Wann sollte die erste Untersuchung erfolgen? Bereits im Kleinkindalter kann ein Augenarzt oder Optometrist feststellen, ob eine Fehlsichtigkeit oder Amblyopie vorliegt.
Wie oft sind Kontrollen notwendig? Mindestens einmal pro Jahr, besonders wenn bereits eine Myopie oder andere Sehstörungen bestehen.
Unser Fazit
Die Sehkraft unserer Kinder ist ein kostbares Gut! Mit regelmäßigen Augenuntersuchungen, rechtzeitiger Amblyopie-Therapie und moderner Myopie-Kontrolle durch MiYOSMART-Gläser oder spezielle Kontaktlinsen kann das Sehvermögen nachhaltig geschützt werden. So ermöglichen wir unseren Kindern beste Voraussetzungen für Schule, Freizeit und eine gesunde visuelle Zukunft.

Vergrößernde Sehhilfen – Mehr Lebensqualität trotz Sehbeeinträchtigung
Wenn herkömmliche Brillen oder Kontaktlinsen nicht mehr ausreichen, können vergrößernde Sehhilfen helfen, den Alltag zu erleichtern und die Selbstständigkeit zu erhalten. Diese speziellen Hilfsmittel sind besonders für Menschen mit starker Sehbeeinträchtigung durch Erkrankungen wie Makuladegeneration, diabetische Retinopathie oder Sehnerverkrankungen geeignet.
Wann sind vergrößernde Sehhilfen sinnvoll?
- Wenn das Lesen von Zeitungen, Büchern oder Preisschildern schwierig wird
- Wenn Gesichter, TV-Bilder oder Details nicht mehr klar erkennbar sind
- Wenn herkömmliche Brillen nicht mehr ausreichen, um das Sehen zu verbessern
Welche vergrößernden Sehhilfen gibt es?
- Lupenbrillen & Fernrohrbrillen – Spezialbrillen mit integrierter Vergrößerung für Alltag und Freizeit
- Hand- und Standlupen – Ideal zum Lesen von Texten oder für Detailarbeiten
- Elektronische Lupen & Bildschirmlesegeräte – Digitale Hilfsmittel mit einstellbarer Vergrößerung und Kontrastverstärkung
- Spezielle Bildschirm- und Vorlesesysteme – Unterstützende Technologien für Menschen mit starker Sehschwäche
Individuelle Beratung und Anpassung
Da jede Sehbeeinträchtigung unterschiedlich ist, bieten wir in unserer Praxis eine persönliche Beratung an. Gemeinsam finden wir die optimale Lösung für Ihre Bedürfnisse – damit Sie weiterhin aktiv am Leben teilnehmen können!
Vereinbaren Sie einen Termin, um mehr über vergrößernde Sehhilfen zu erfahren. Wir helfen Ihnen gerne weiter!
Botoxtherapie – Sanfte Faltenreduzierung für ein frisches Aussehen
Die Botox-Behandlung ist eine schnelle, sichere und effektive Methode, um Mimikfalten im Gesicht zu glätten und ein natürlich frisches Aussehen zu bewahren.
Botox (Botulinumtoxin) ist ein muskelentspannender Wirkstoff, der gezielt in bestimmte Gesichtsmuskeln injiziert wird. Dadurch entspannt sich die Muskulatur, und die darüber liegende Haut glättet sich. Die natürliche Mimik bleibt erhalten, während störende Falten reduziert werden.
Welche Falten können mit Botox behandelt werden?
- Zornesfalten (zwischen den Augenbrauen)
- Stirnfalten (horizontale Linien auf der Stirn)
- Krähenfüße (Lachfalten um die Augen)
- Bunny Lines (feine Falten an der Nasenwurzel)
- Marionettenfalten (Mundwinkelbereich)
Wie läuft die Behandlung ab?
- Beratung & Analyse – Wir besprechen Ihre Wünsche und prüfen, welche Bereiche behandelt werden können.
- Schnelle Injektion – Die Behandlung dauert nur wenige Minuten, ist nahezu schmerzfrei und benötigt keine Betäubung.
- Wirkung & Haltbarkeit – Die ersten Ergebnisse sind nach 3–7 Tagen sichtbar, die volle Wirkung tritt nach ca. 2 Wochen ein. Das Ergebnis hält in der Regel 3–6 Monate.
Vorteile der Botoxtherapie
- Sanfte Glättung der Haut, ohne unnatürlich zu wirken
- Schnelle Behandlung ohne Ausfallzeit
- Vorbeugung neuer Falten, indem Mimikbewegungen reduziert werden
- Erfrischtes, entspanntes Aussehen
Unser Fazit
Die Botoxtherapie ist eine sichere und effektive Methode, um Falten sanft zu reduzieren und die natürliche Schönheit zu bewahren. Lassen Sie sich beraten, ob diese Behandlung für Sie geeignet ist!

Die Pellevé Behandlung
Die Ausgangssituation:
mit fortschreitenden Jahren lässt die Spannung der Haut nach und die kollagenen Fasern verlieren an Elastizität. Erste Anzeichen von Hauterschlaffung und feinen Knitterfältchen sind die Folge.
Immer mehr Menschen möchten dieser Entwicklung entgegentreten und wünschen sich ein strafferes, frischeres Erscheinungsbild. Pellevé ist besonders geeignet, um ersten Anzeichen der Hautalterung entgegenzuwirken, kann aber auch sehr effektiv in Kombination mit Botox, Hyaluronsäure oder anderen Fillern bei einer fortgeschrittenen Hautalterung eingesetzt werden.
Die Pellevé Behandlung
Die Pellevé Behandlung
zeichnet sich gegenüber anderen Verfahren der Faltenbehandlung dadurch aus, dass sie ohne chirurgischen Eingriff und ohne körperfremde Zusatzstoffe arbeitet. Nach der Behandlung können Sie sofort wieder in Ihren normalen Tagesablauf zurückkehren.
Die Vorteile auf einen Blick
- Sichtbare Behandlungsergebnisse
- Keine Abheilungsphase
- Keine Ausfallzeiten
- Sichere Technologie
- Langjährige Erprobungs- und Forschungsbasis
- Kombinationen mit anderen Methoden zur Hautverjüngung sind möglich
Fragen Sie uns! Wir beraten Sie gerne.